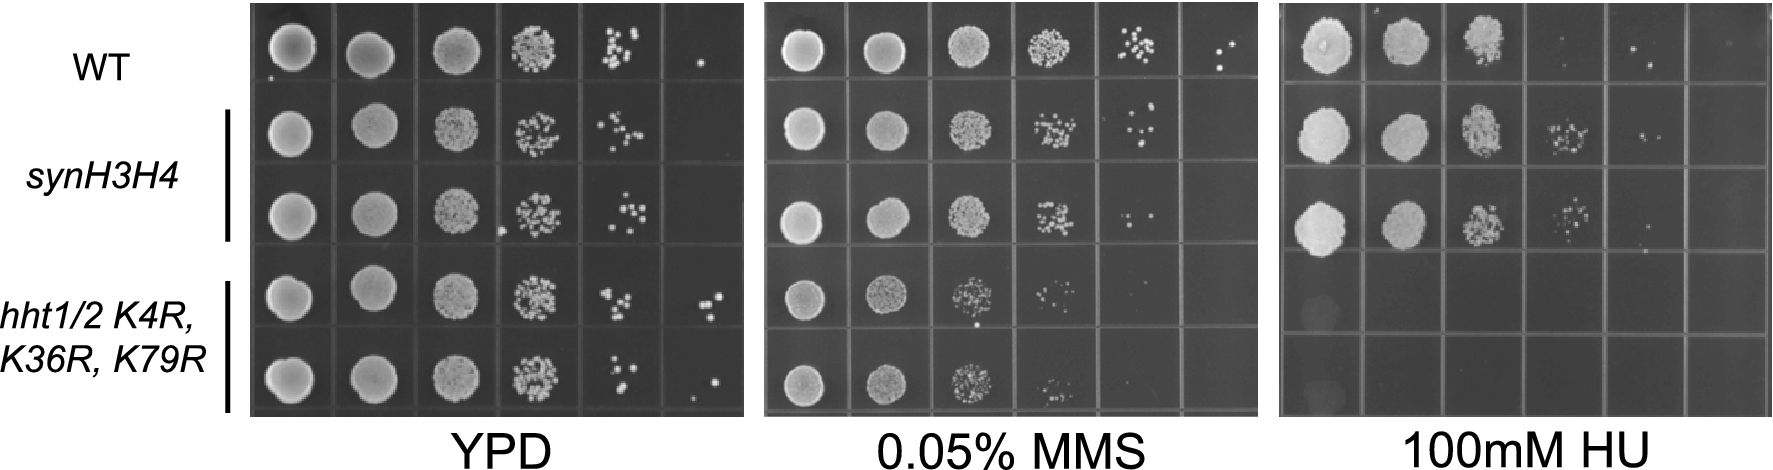
Figure 4

Figure 4
From: A CRISPR-Cas9 based shuffle system for endogenous histone H3 and H4 combinatorial mutagenesis
Confirmation of MMS and HU sensitivity of synH3H4 strain and histone H3 K4R–K36R, K79R mutant. WT stain and two biological replicates of each mutant were grown in YPD overnight at 30 °C. Serial tenfold dilutions of OD600 = 1 yeast cultures were spotted onto YPD for 2 days, YPD with 0.05% MMS for 3 days, or YPD with 100 mM HU and incubated for 3 days at 30 °C.
